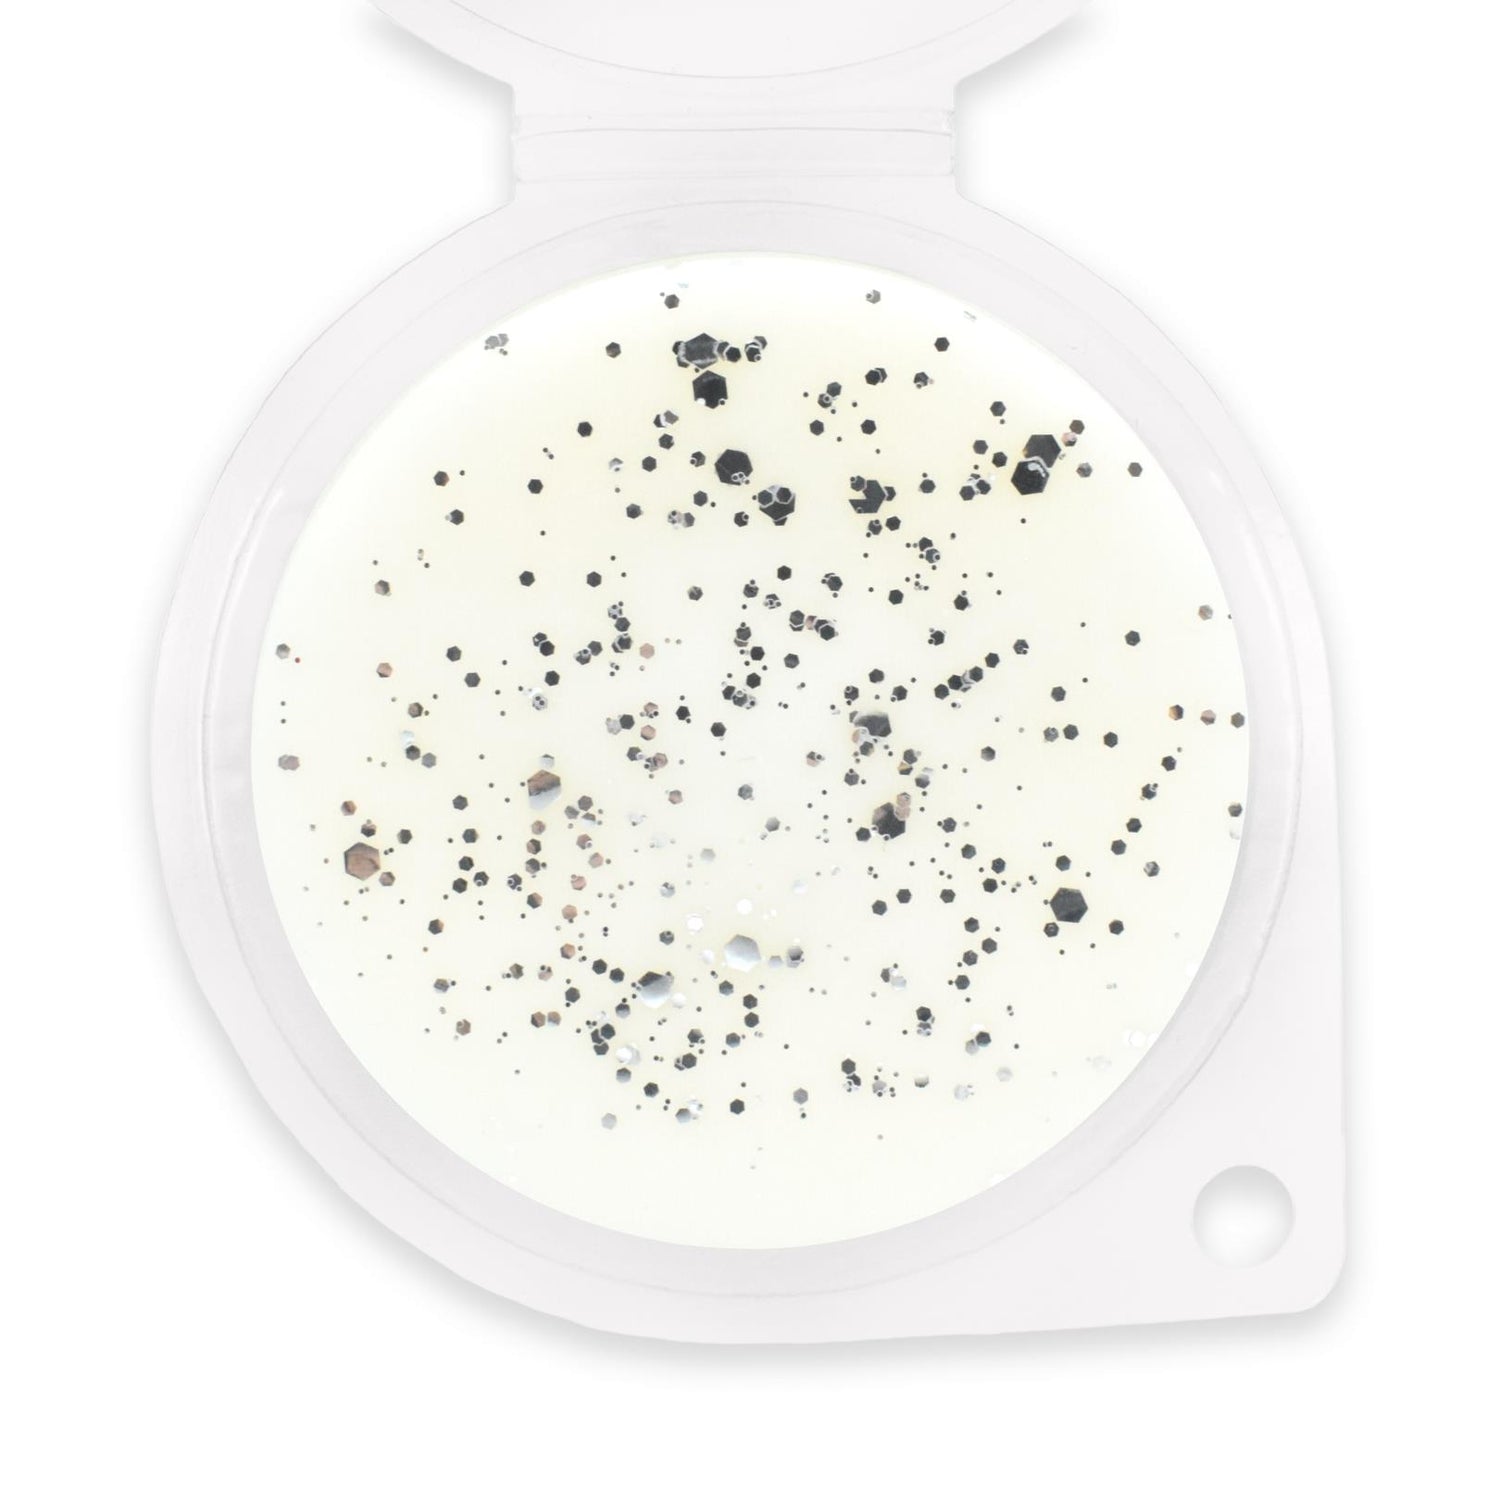
Sassy Shop Wax Melt Pot 50g - White Linen

Sassy Shop Wax Melt Pot 50g - White Linen
Sassy Shop Wax Melt Pot 50g - White Linen is backordered and will ship as soon as it is back in stock.
Couldn't load pickup availability
Specially created using an original soy wax blend and the best quality concentrated fragrance oil, this wax melt pot contains 5 pieces of heart shaped wax.
Break off one or two heart pieces from your wax melt and place in your tea light or electric wax melt warmer.
- 50g Pot
- Soy Wax Blend
- Vegan Friendly
- Hand Made in UK
Fragrance - White Linen: A pure and airy fragrance reminiscent of clean cotton blowing in the breeze.